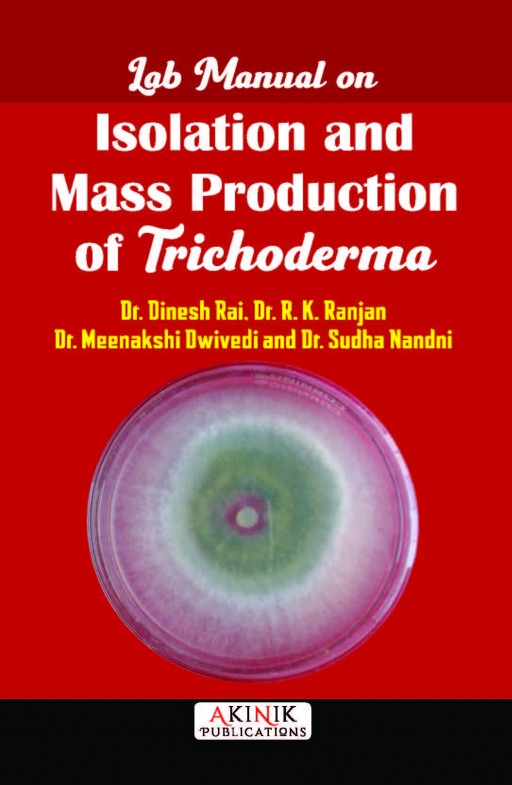
Lab Manual on Isolation and Mass Production of Trichoderma

India achieved food security by adopting high-yielding seed varieties, fertilizers, and pesticides to enhance crop productivity. However, the overuse of pesticides has led to significant environmental damage, affecting both human and ecological health. In response to these challenges, alternative approaches to plant disease management are gaining traction. One such approach is the use of microorganisms, with Trichoderma emerging as a versatile microbe capable of addressing a range of plant stresses, including diseases, soil salinity, and drought. Trichoderma's multifaceted role in enhancing plant growth, disease control, and promoting a cleaner environment offers a sustainable solution for agriculture. Despite the theoretical knowledge of biocontrol agents among students, farmers, and extension workers, practical application remains limited. To bridge this gap, the need for hands-on training in mass multiplication, bio-agent isolation, and biological control techniques has become crucial. This training manual, developed by the Department of Plant Pathology & Nematology, PG College of Agriculture, Dr. Rajendra Prasad Central Agricultural University, Pusa, aims to provide students and professionals with comprehensive guidance on the practical aspects of biological control. By offering an introductory understanding of biological control and essential lab techniques, this manual serves as a vital resource for students, plant pathologists, biologists, and anyone pursuing a career in biological control.